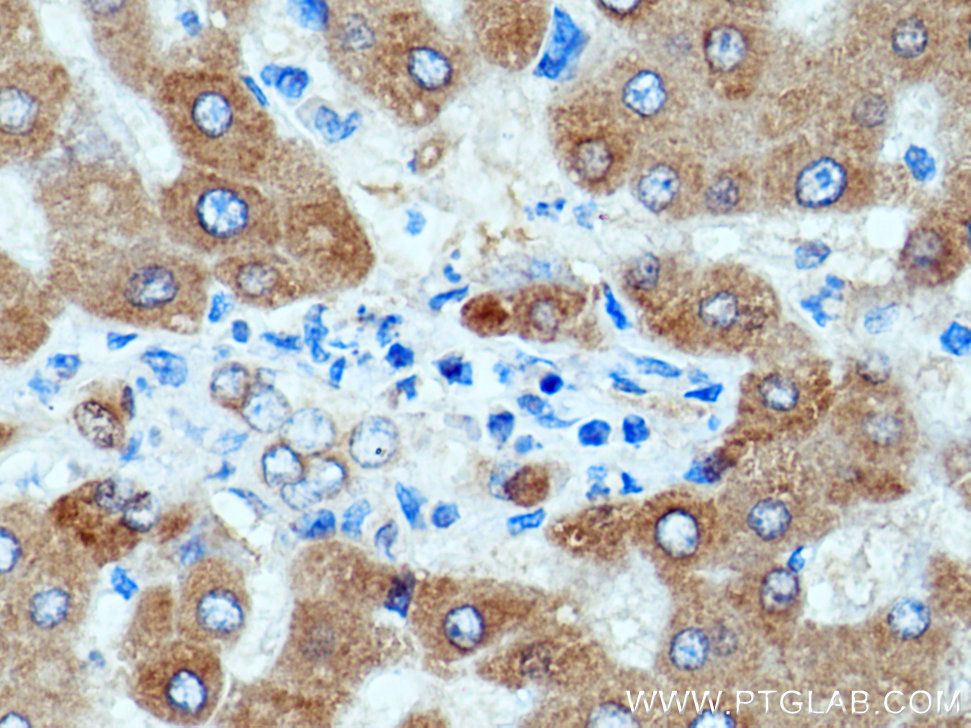

验证数据展示
经过测试的应用
| Positive WB detected in | HuH-7 cells, HepG2 cells, human plasma |
| Positive IP detected in | human plasma |
| Positive IHC detected in | human liver tissue Note: suggested antigen retrieval with TE buffer pH 9.0; (*) Alternatively, antigen retrieval may be performed with citrate buffer pH 6.0 |
| Positive IF/ICC detected in | HeLa cells |
| Positive FC (Intra) detected in | HepG2 cells |
推荐稀释比
| 应用 | 推荐稀释比 |
|---|---|
| Western Blot (WB) | WB : 1:1000-1:4000 |
| Immunoprecipitation (IP) | IP : 0.5-4.0 ug for 1.0-3.0 mg of total protein lysate |
| Immunohistochemistry (IHC) | IHC : 1:50-1:500 |
| Immunofluorescence (IF)/ICC | IF/ICC : 1:50-1:500 |
| Flow Cytometry (FC) (INTRA) | FC (INTRA) : 0.25 ug per 10^6 cells in a 100 µl suspension |
| It is recommended that this reagent should be titrated in each testing system to obtain optimal results. | |
| Sample-dependent, Check data in validation data gallery. | |
产品信息
11992-1-AP targets Angiotensinogen/AGT in WB, IHC, IF/ICC, FC (Intra), IP, CoIP, ELISA applications and shows reactivity with human samples.
| 经测试应用 | WB, IHC, IF/ICC, FC (Intra), IP, ELISA Application Description |
| 文献引用应用 | WB, IHC, IF, CoIP |
| 经测试反应性 | human |
| 文献引用反应性 | human, mouse, rat |
| 免疫原 |
CatNo: Ag2632 Product name: Recombinant human AGT protein Source: e coli.-derived, PGEX-4T Tag: GST Domain: 136-485 aa of BC011519 Sequence: PTAVFGTLASLYLGALDHTADRLQAILGVPWKDKNCTSRLDAHKVLSALQAVQGLLVAQGRADSQAQLLLSTVVGVFTAPGLHLKQPFVQGLALYTPVVLPRSLDFTELDVAAEKIDRFMQAVTGWKTGCSLTGASVDSTLAFNTYVHFQGKMKGFSLLAEPQEFWVDNSTSVSVPMLSGMGTFQHWSDIQDNFSVTQVSFTESACLLLIQPHYASDLDKVEGLTFQQNSLNWMKKLSPRTIHLTMPQLVLQGSYDLQDLLAQAELPAILHTELNLQKLSNDRIRVGEVLNSIFFELEADEREPTESTQQLNKPEVLEVTLNRPFLFAVYDQSATALHFLGRVANPLSTA 种属同源性预测 |
| 宿主/亚型 | Rabbit / IgG |
| 抗体类别 | Polyclonal |
| 产品类型 | Antibody |
| 全称 | angiotensinogen (serpin peptidase inhibitor, clade A, member 8) |
| 别名 | AGT, Angiotensinogen, Serpin A8, SERPINA8, Alpha 1 antiproteinase |
| 计算分子量 | 485 aa, 53 kDa |
| 观测分子量 | 53 kDa |
| GenBank蛋白编号 | BC011519 |
| 基因名称 | AGT |
| Gene ID (NCBI) | 183 |
| RRID | AB_2225452 |
| 偶联类型 | Unconjugated |
| 形式 | Liquid |
| 纯化方式 | Antigen affinity purification |
| UNIPROT ID | P01019 |
| 储存缓冲液 | PBS with 0.02% sodium azide and 50% glycerol, pH 7.3. |
| 储存条件 | Store at -20°C. Stable for one year after shipment. Aliquoting is unnecessary for -20oC storage. |
背景介绍
Angiotensinogen is a precursor of angiotensin II (Ang II), is expressed and synthesized largely in the liver and is cleaved by the enzyme renin in response to lowered blood pressure. It has a key role in mediating vascular constriction and regulating salt and fluid homeostasis. The resulting product, angiotensin I, is then cleaved by angiotensin converting enzyme (ACE) to generate the physiologically active enzyme angiotensin II. Mutations in this gene are associated with susceptibility to essential hypertension, and can cause renal tubular dysgenesis, a severe disorder of renal tubular development. Defects in this gene also have been associated with non-familial structural atrial fibrillation, and inflammatory bowel disease.
实验方案
| Product Specific Protocols | |
|---|---|
| IF protocol for Angiotensinogen/AGT antibody 11992-1-AP | Download protocol |
| IHC protocol for Angiotensinogen/AGT antibody 11992-1-AP | Download protocol |
| IP protocol for Angiotensinogen/AGT antibody 11992-1-AP | Download protocol |
| WB protocol for Angiotensinogen/AGT antibody 11992-1-AP | Download protocol |
| Standard Protocols | |
|---|---|
| Click here to view our Standard Protocols |
发表文章
| Species | Application | Title |
|---|---|---|
Matrix Biol Proteome-wide and matrisome-specific atlas of the human ovary computes fertility biomarker candidates and open the way for precision oncofertility. | ||
Hypertension Attenuation of brain damage and cognitive impairment by direct renin inhibition in mice with chronic cerebral hypoperfusion. | ||
Biochem Pharmacol Downregulation of spinal angiotensin converting enzyme 2 is involved in neuropathic pain associated with type 2 diabetes mellitus in mice. | ||
FASEB J Sperm immotility is associated with epididymis metabolism disorder in mice under obstructive azoospermia | ||
Cells Effect of Hydrocortisone on Angiotensinogen (AGT) Mutation-Causing Autosomal Recessive Renal Tubular Dysgenesis. | ||
Phytomedicine Epiberberine ameliorated diabetic nephropathy by inactivating the angiotensinogen (Agt) to repress TGFβ/Smad2 pathway. |